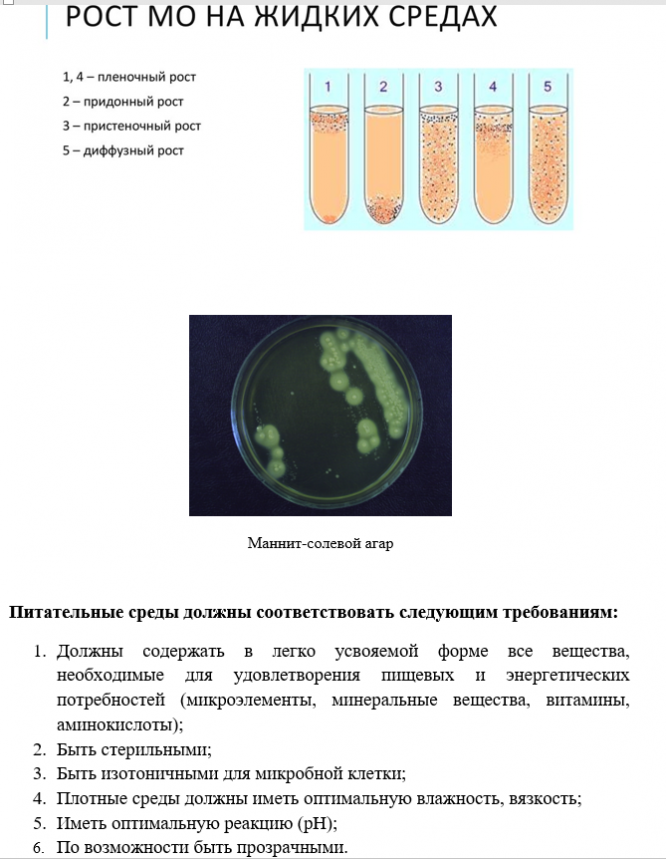

Для студентов СГМУ по предмету МикробиологияХарактеристика питательных средХарактеристика питательных сред
2021-02-232021-02-23СтудИзба
Лекции: Характеристика питательных сред
Описание
Характеристики лекций
Список файлов
Комментарии
Нет комментариев
Стань первым, кто что-нибудь напишет!

СГМУ
Spes